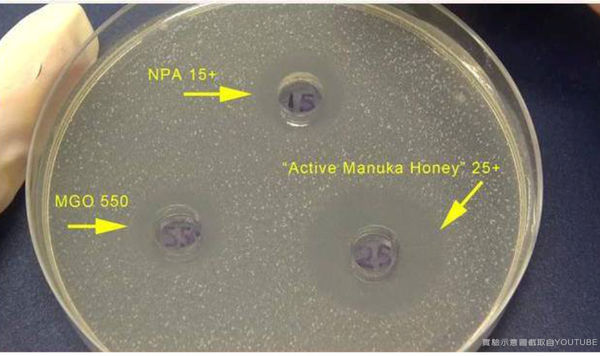
B2-Original

平常大家都如何保養自己呢?
隨著年紀的增長也越能感受到歲月的痕跡...
尤其是生了兩個小孩之後,明顯的發現自己的體力各方面都變差了
很容易累也很容易想睡...
但對於全職媽媽的我來說,一天24小時真的不夠用~
每天除了要照顧小孩,還有忙不玩的家務事,加上偶爾有文章要趕...
不要說保養,有時候想要好好睡一覺都是奢侈的呀>"<
所以這個時候保養就得講求既簡單快速方便的原則啦!
除了外在的塗塗抹抹,內在的保養也是很重要呢!
※此為廠商邀約文,內容為晴麻真實分享
這次晴麻要和大家分享來自紐西蘭的小鎮蜂蜜-100%麥蘆卡蜂蜜喔!
外包裝沒有多餘的裝飾,簡單大方~不論自用或是拿來送禮都很體面^^b
這次晴麻拿到的是小鎮蜂蜜的【麥蘆卡蜂蜜養身雙罐組】
內容物:天然活性25+麥蘆卡蜂蜜(250g)(左‧白蓋)+乳化活性15+麥蘆卡蜂蜜(250g)(右‧黑蓋)
外觀為油亮的深黑色,罐瓶身和瓶蓋皆是塑膠製成
大家在挑選市面上的麥蘆卡蜂蜜時,是否有注意到
盛裝蜂蜜的罐子都是深色包裝,且罐子瓶身和瓶蓋皆是塑膠製成的呢?
主要是因為蜂蜜為弱酸性,會侵蝕金屬製品,因此玻璃罐上的鐵蓋會影響蜂蜜品質
黑色瓶身則可以阻擋陽光的紫外線,以及避免溫度太高而傷害蜂蜜中的營養成份
盒內附的木製湯匙,也很精美有質感
天然蜜和乳化蜜其實成份皆相同,都是取自於有機紐西蘭麥蘆卡樹
不含任何甜味化學成份、農藥殘留和動物用藥汙染
這兩者最大的差別就在於外觀以及質地
天然蜜(白蓋)的質地是較為稀的溶液狀
乳化蜜(黑蓋)是利用純正蜂蜜結晶的原理
讓天然蜜在低溫下結晶,並將結晶塊磨細
質地較為濃稠似膏狀
首次嚐了小鎮蜂蜜的麥蘆卡蜂蜜,覺得甜度十分的高
味道也與一般蜂蜜有些不太一樣~比較濃郁
就算泡在水中稀釋飲用,也不減它甜蜜的風味
天然蜜和乳化蜜這兩者比較起來
晴麻個人會喜歡天然蜜入口即化的順滑的口感
小朋友的話應該晴麻覺得應該會比較喜歡乳化蜜那沙沙帶有細緻顆粒的口感
像晴姐姐就覺得跟在吃糖一樣~很有存在感呵
順便告訴大家一個嗜甜者必讀的蜂蜜的小常識
大家知道嗎?等量的蜂蜜和砂糖。蜂蜜的甜度是砂糖的三倍(麥蘆卡蜂蜜可能到達四倍)
達到相同的甜度,使用蜂蜜可以減少25%的熱量喔!
想吃甜食但又不想吃進過多的卡路里
不妨選擇甜度高但熱量相對較低的蜂蜜
Village Honey小鎮蜂蜜的麥蘆卡蜂蜜來自純淨無汙染的紐西蘭
品牌創始於紐西蘭的一位蜂農
創辦人Chris Elmsly以自家種植的麥蘆卡樹旁放置蜂箱,好讓野生蜂蜜前來築巢製蜜
每年夏季則聘用到紐西蘭度假打工的年輕人來採收蜂蜜
雖然年產量和品牌知名度沒有大品牌來得多和響亮
但他秉持著蜂蜜就是要以最天然最原始的型態售出的原則
生產過程中只經過雜質過濾,並沒有高溫消毒的步驟~所以能夠保留天然蜂蜜最原始、最完整的營養!
小鎮蜂蜜的麥蘆卡蜂蜜的進口商,本身也是一位媽媽呢!
去年帶著兩個孩子到澳洲旅行期間,認識了小鎮蜂蜜的麥蘆卡蜂蜜
並強烈感受到麥蘆卡蜂蜜對人體來說是很好的保健品,因而將它引進台灣
希望能讓這樣的好產品推廣給更多人知道!
小鎮蜂蜜官網上也提供了SGS認證以及活性測試示意圖(點開有大圖)
讓消費者能夠安心食用
晴麻這邊也整理了一些許多人對蜂蜜的Q&A供大家參考
Q:現在天氣炎熱,蜂蜜是否需要冷藏?
A:蜂蜜水分含量少,且具有強大的殺菌力,細菌和酵母菌都不能在蜂蜜中存活,因此蜂蜜並不需要放入冰箱保存,只需要放置在乾燥、陰涼的地方即可。
Q:嬰幼兒可以吃蜂蜜嗎?
A:所有的蜂蜜皆為昆蟲酵素製品,裡頭很有可能含有肉毒桿菌,一歲以下的嬰幼兒腸胃道尚未發展完全,也較為脆弱,很容易導致肉毒桿菌中毒的現象,建議不要食用蜂蜜和蜂蜜相關的製品。
Q:要用來泡蜂蜜的開水溫度要怎麼拿捏呢?
A:蜂蜜加熱並不會產生毒素,但直接沖泡熱水,會破壞蜂蜜本身的營養素和其活性。麥蘆卡蜂蜜含有維生素B1、B2、B5、B6、C、K、E尼克酸、葉酸,以及礦物質磷、錳、鉀、鈉、銅等,還有4-7種蛋白質、胺基酸、多酚等多種營養素,通常會建議使用冰冷或是低於40度以下的溫開水。
Q:何時飲用蜂蜜水最適宜?
A:建議下午3-4點之間,這個時間這值午餐和晚餐之間,也屬身體最疲累的時候。適時的補充一杯蜂蜜水,其葡萄糖和熱量能增強體力。
Q:麥蘆卡蜂蜜和一般蜂蜜有何不同?
A:比起一般蜂蜜,麥蘆卡蜂蜜可以應用於多方面,而麥蘆卡與一般蜂蜜最大的不同就在於蜂蜜的「活性」!活性數值越高代表其抗菌能力越高。世界上所有的蜂蜜都含有抗菌成份,所以早在千年前就被埃及人當作防腐劑保存木乃伊,因為抗菌所使屍體不會腐爛。但是所有抗菌成份都會因為與空氣、熱能接觸,還有其他環境中的不穩定因素而產生變化,使得蜂蜜的抗菌力受到影響,唯有麥蘆卡不同研究發現其抗菌力是穩定的且不會改變的!
另外偷偷告訴大家一個測試蜂蜜是否純正的小撇步!
將你手邊的蜂蜜挖一小湯匙放入冰箱
如果會結晶代表就是純正葡萄糖的蜂蜜嚕...反之則是人工果糖製成的蜂蜜
實驗一下就知道~小鎮蜂蜜-麥蘆卡蜂蜜果真純正又天然:P
麥蘆卡蜂蜜的好處多多,含豐富的維生素和礦物質
有「最天然的健康補給」的美譽!
現在我也都會直接單吃或是搭配一些簡單的料理呢!
接下來就跟大家分享一些蜂蜜的吃法吧:P
【蜂蜜檸檬水】
材料:
1.40度C以下的冷(溫)開水
2.切片檸檬數片
3.活性25+麥蘆卡天然蜂蜜
建議比例:250C.C.的檸檬水+3克蜂蜜(木湯匙滿匙)
蜂蜜泡水是最常見也最簡單方便的吃法。
記得小時後,每當夏天,媽咪都在冰箱放一罐冰冰涼涼的蜂蜜水
好讓我和弟妹放學回來後能夠解渴
所以蜂蜜對我和弟妹來說真的也有童年的味道呵
晴麻習慣事先泡一大壺的檸檬水,之後要喝的時候再倒入杯中加入蜂蜜
蜂蜜泡水會建議使用天然麥蘆卡蜂蜜,比較容易溶解於水
因為是稀釋過的,泡了也不一定會馬上喝完
蜂蜜的量就比較沒有限定
可以依照個人甜度的喜好再作調整喔!
但記得一天最多不要超過30克
製成蜂蜜水蜂蜜應該然後甜味依然濃郁
夏天來杯的蜂蜜檸檬水~解渴又透心涼!
【蜂蜜軟法】
食材:
1.軟法一條
2.活性15+麥蘆卡乳化蜂蜜 1.5-3克(木湯匙半-滿匙)
個人非常推薦軟法麵包塗抹蜂蜜!
因為原味軟法本身沒有包餡,吃起來也沒有太多的甜味
反而能中和甜度高的蜂蜜~超級對味好吃>O<
如果是要塗抹在麵包類上。會建議使用質地較濃稠的乳化蜜
就仿照一般果醬去塗抹,也不會滴的到處都是囉XD
因為是要給兩姐妹吃的(小朋友比較喜歡吃甜),所以晴麻蜂蜜就是直接塗滿一整個木湯匙的量
如果怕會太甜,可以先在麵包上塗上一層無糖奶油再抹上蜂蜜就OK哩!
小朋友一般會比較喜歡吃糖果之類的甜食
但只要做父母的一定都知道,糖多吃無益!
不但會影響體內脂肪的消耗造成脂肪推積,也會影響孩童鈣質的代謝容易缺鈣
但要小朋友都不吃糖是不太可能~我這作媽的也不忍心><
不如就利用天然的蜂蜜取代熱量高的砂糖和人工甜味劑
讓小朋友嚐到甜頭,也能顧到健康^+++^
晴姐姐表示她也想要試試蜂蜜軟法DIY~哈
認真的小女孩最可愛>///<
大口滿足!XD
家裡的兩姊妹對麥蘆卡蜂蜜的接受度很高呢:P
就這樣一連吃了好幾塊蜂蜜麵包!
【蜂蜜香蕉鬆餅(煎餅)】
食材:
1.熟的香蕉 一條
2.雞蛋 1-2顆(可以根據香蕉的大小來調配)
3.雪印奶油(用一般沙拉油也是可以,但晴麻個人覺得用奶油煎出來的成品會比較香>///<
4..活性25+麥蘆卡天然蜂蜜
這是前陣子很夯的香蕉鬆餅食譜~
原食譜只有雞蛋和香蕉,非常適合像我一樣的懶媽媽呀!哈
也可以加入牛奶或是豆漿來增加它的營養價值
有的人還會再放入麵粉、鬆餅粉和白砂糖等,吃起來又有不同的口感和風味~
晴麻是比較講求方便快速的原則,所以食材的準備上一切從簡啦XD
就看個人喜好囉!
作法:
1.將香蕉剝皮後切小塊
2.之後將香蕉和雞蛋一同倒入果汁機或是使用攪拌棒打勻成香蕉糊
記得香漿糊不能太稀,要濃稠一點才煎得起來
如果覺得打兩顆蛋太過於稀,可以再多加一些香蕉進去
3.熱鍋並放入適量的雪印奶油
如果家裡有不沾鍋,其實可以不用放油
因為晴麻家的用的是平底鍋,所以就要加點油下去煎才不會黏鍋喔!
4.待奶油香味出來後,即可將香蕉糊倒進鍋內
記得要開平均的小火慢煎
煎至兩面都呈現金黃色、帶有點酥脆焦焦的感覺~就可以起鍋囉!
5.最後淋上可口美味的天然蜜就大功告成啦!
雖然煎出來的成品沒有原作來得漂亮=沒有賣相,但味道一樣好吃啦XD
吃起來超級軟嫩,很適合作為小朋友的下午茶點心^^
希望所有人的人妻媽咪在忙於家庭的同時,也都能夠多愛自己一些!
這樣才有健康和活力與小搗蛋們奮戰呀>O<
最後就是晴麻的讀者回饋時間囉~~~:P
凡於小鎮蜂蜜的麥蘆卡官網訂購者,只要在備註欄上註明是「晴麻介紹」就可享免運的優惠喔!
【產品資訊】
Village Honey小鎮蜂蜜的100%麥蘆卡蜂蜜-麥蘆卡蜂蜜養身雙罐組
內容物:天然活性25+麥蘆卡蜂蜜(250g)+乳化活性15+麥蘆卡蜂蜜(250g)
※喜歡晴麻的文章也請不吝給個讚&留言呦^^
![]() |
-------Love&Happiness-------人妻雙寶媽咪的我,用文字和照片玩味生活;跟著小資的晴麻一家用心玩樂嚐遍天下!

別忘了在「讚」的選單下勾選「接收通知」,好玩好吃的資訊就能隨時不漏接嚕!